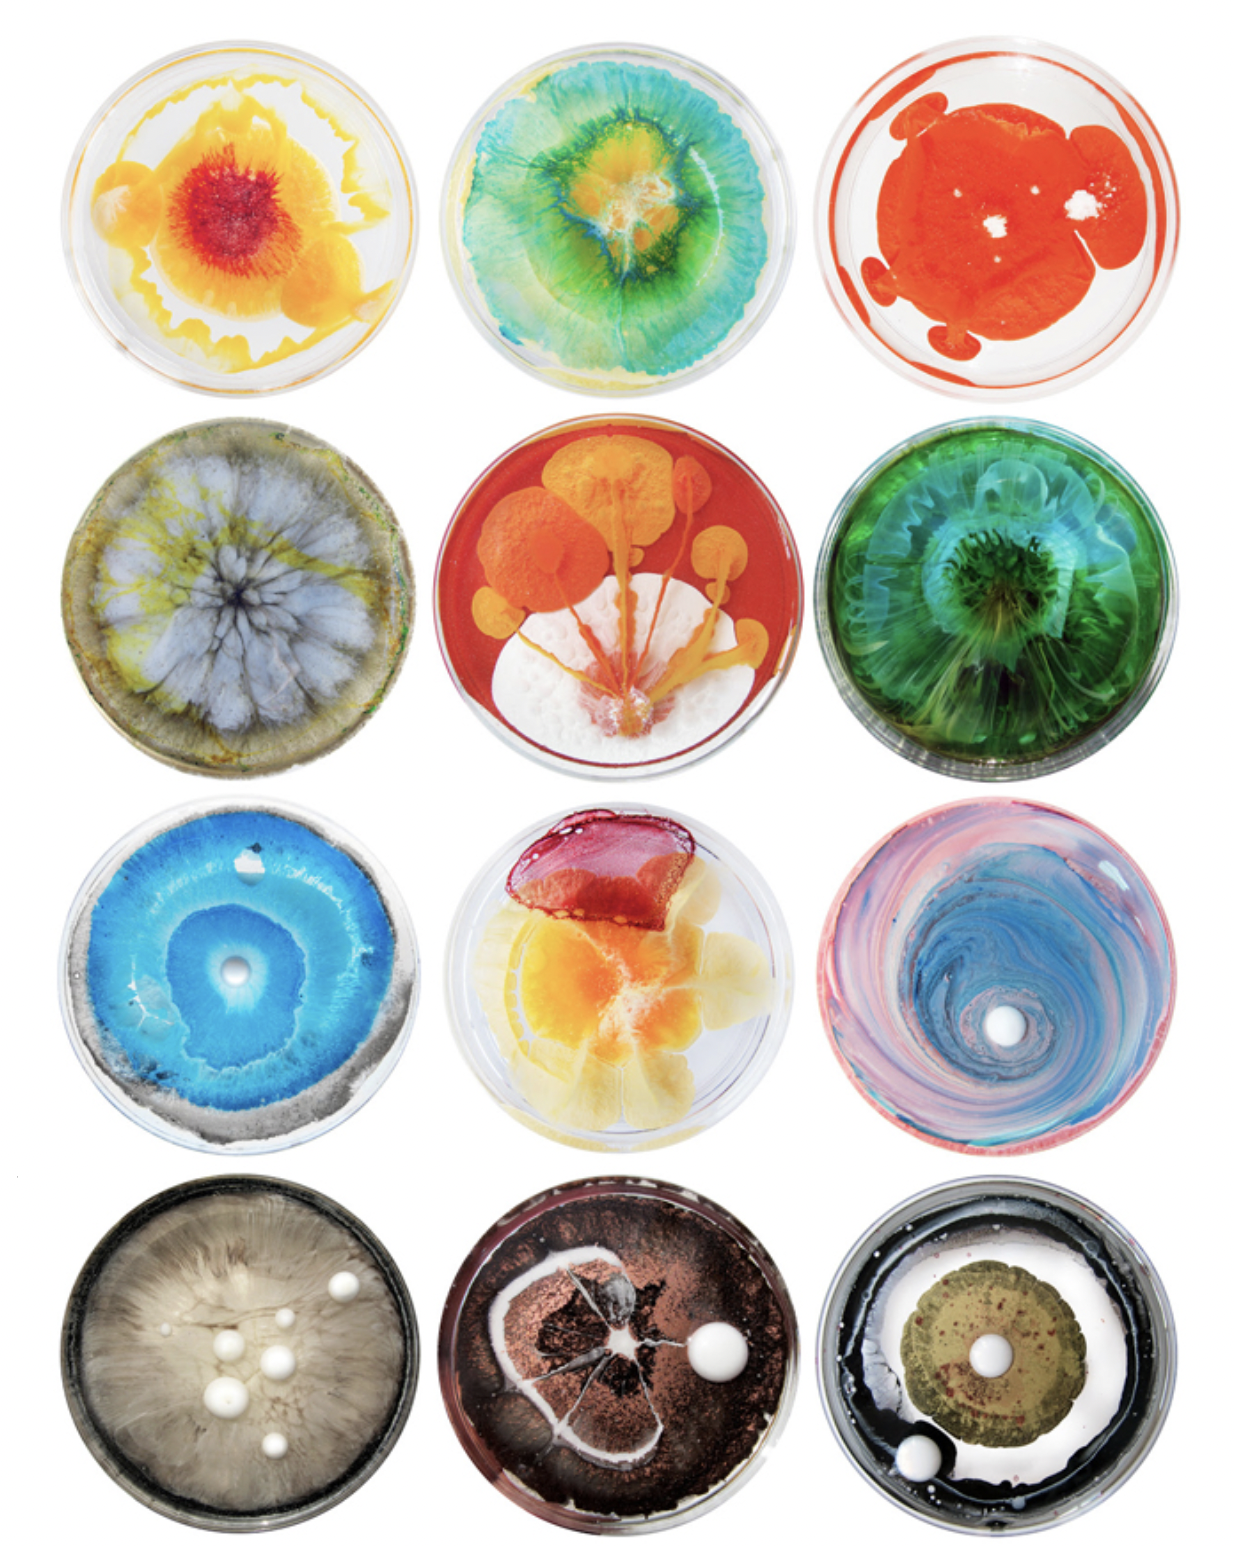
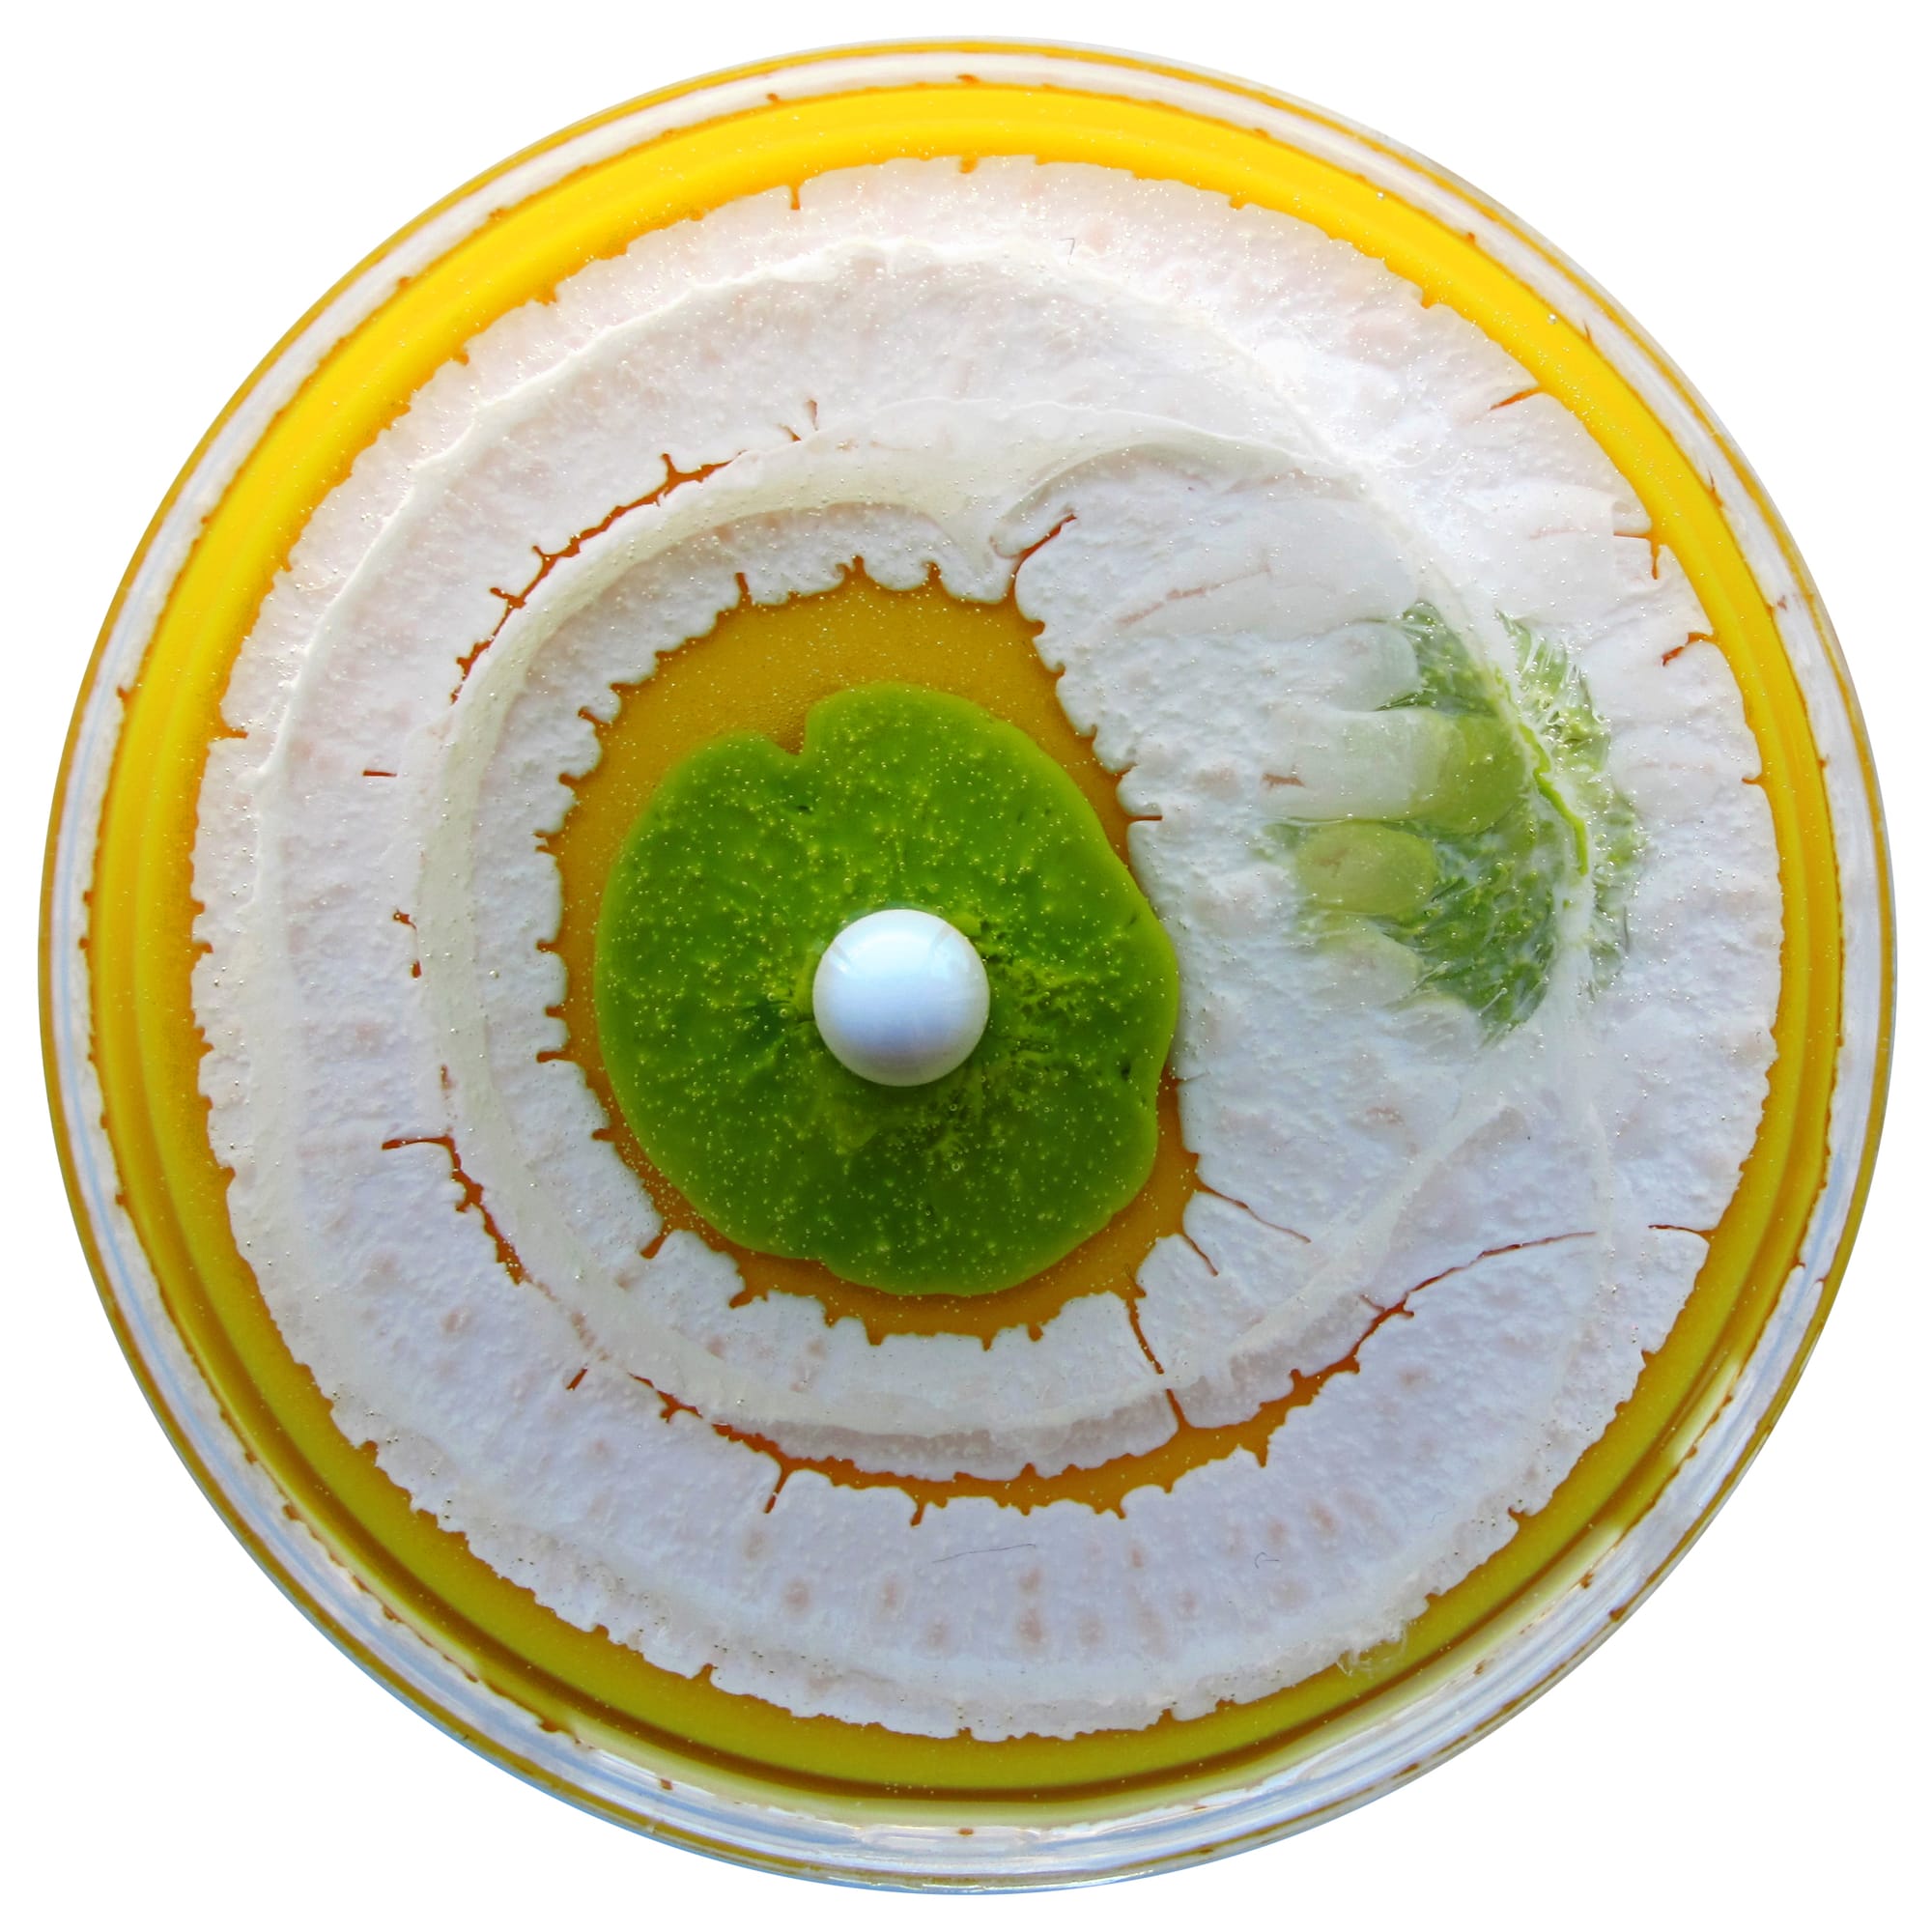

Petrischalen
Op de één of andere manier ben ik vrij snel om als dingen kleurrijk en serieel zijn. Dus hallo, Klara Reis. Ze postte tussen 2009 en 2023 (bijna) elke dag beschilderde petrischalen. Awesome. En in bepaalde constructies helemaal amazing.